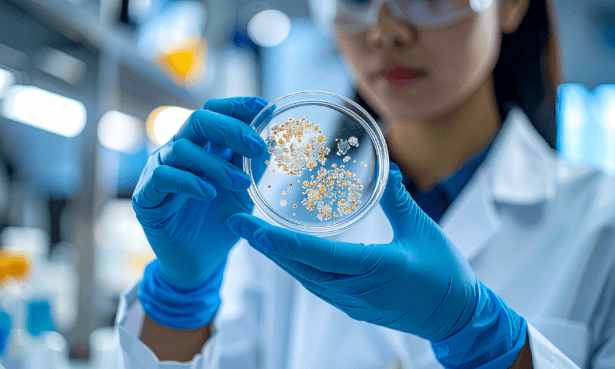

Откриха бактерия, резистентна на антибиотици, в пещера в Румъния
Замръзнала бактерия на 5 хиляди години, която е резистентна на използваните в наши дни антибиотици, бе открита в ледена пещера в Румъния. Щамът на бактерията Psychrobacter SC65A.3 е открит в Scarisoara – една от най-големите ледени пещери в Румъния. Тя може да оцелее хилядолетия при екстремни условия: под дебели слоеве лед, в пермафроста, в дълбините на моретата и ледниковите езера. От анализа на румънските учени става ясно, че щамът е устойчив на 10 антибиотика от 8 различни класа.
Бактерията е носител на повече от 100 резистентни гени
Авторът на проучването Кристина Пуркареа пояснява, че Psychrobacter SC65A.3 е носител на повече от сто гени, от които зависи резистентността й. Леденият блок, в който е открита е на около 13 хиляди години и с обем от 100 хиляди кубични метра.
Екипът прави сондаж на дълбочина 25 метра, след което изследва ледени фрагменти, в които открива различни бактериални щамове. С помощта на метода за геномно секвениране са идентифицирани гените, които правят бактерията устойчива на студ и антибиотични препарати.

Psychrobacter SC65A.3 е резистентна на антибиотици за лечение на туберкулоза и инфекции на пикочните пътища
Пуркареа допълва, че антибиотиците, срещу които е резистентна Psychrobacter SC65A.3, се приемат перорално и инжекционно. Те се предписват за сериозни бактериални инфекции като туберкулоза, колит и инфекции на пикочните пътища.
Антимикробната резистентност е природен феномен, който обаче се превърна в заплаха за човечеството заради масовата употреба на антибиотици. Изучаването на микроби като Psychrobacter SC65A.3, открити в хилядолетни ледени пещери дава възможност на учените да проследят как се е развивала антибиотичната им резистентност по естествен път и в естествената им среда още преди да бъдат открити антибиотиците.
Като се има предвид, че 20% от земната повърхност е покрита с лед, а температурата на голяма част от биосферата е много ниска, изследването на студоустойчиви бактерии би имало ключово значение за борбата с климатичните промени.
Резултатите от проучването са публикувани във Frontiers in Microbiology.
|
Антибиотична резистентност » Антибиотик предизвиква резистентност към друг и води до поява на супербактерия » Антибиотична толерантност – скритата бактериална заплаха за човечеството |
Заплахата антибиотична резистентност
Антибиотичната резистентност причинява смъртта на милиони хора по света всяка година. В Европа броят им е над 35 хиляди годишно, като учените предупреждават, че през следващите години той ще продължи да расте.
Няколко са факторите, които обуславят антибиотичната резистентност: застаряващото население, което става по-уязвимо към инфекции, лесното пренасяне на резистентни бактерии от една страна в друга, прекомерната употреба на антибиотици и неефективните мерки за превенция и контрол на инфекциите.
| По данни на СЗО една от шест бактериални инфекции по света е резистентна на стандартно лечение. |
Researchers discover 5,000-year-old bacteria resistant to modern antibiotics: https://www.euronews.com/health/2026/02/17/researchers-discover-5000-year-old-bacteria-resistant-to-modern-antibiotics
НОВИНАТА е свързана към
- Лекарство за високо кръвно налягане унищожава резистентна на антибиотици бактерия
- Имунотерапия ще се бори с устойчивите на антибиотици супербактерии
- Антибиотик предизвиква резистентност към друг и води до поява на супербактерия
- Ибупрофен и парацетамол вероятно увеличават антибиотичната резистентост
- Микробите и бактериите в дъждовните капки бавно ни разболяват
- Тестването за алергия към пеницилин може да помогне срещу антибиотичната резистентност
- Клас антибиотици се справят с мултирезистентни бактерии
- Международните пътувания – фактор за нарастващата в световен мащаб антибиотична резистентност
- Нанотехнология позволява прием на пълен курс антибиотици с една доза
- Поява на сулфонамидите и причина, довела до развитието на резистентност към тази антибиотична група




Коментари към Откриха бактерия, резистентна на антибиотици, в пещера в Румъния